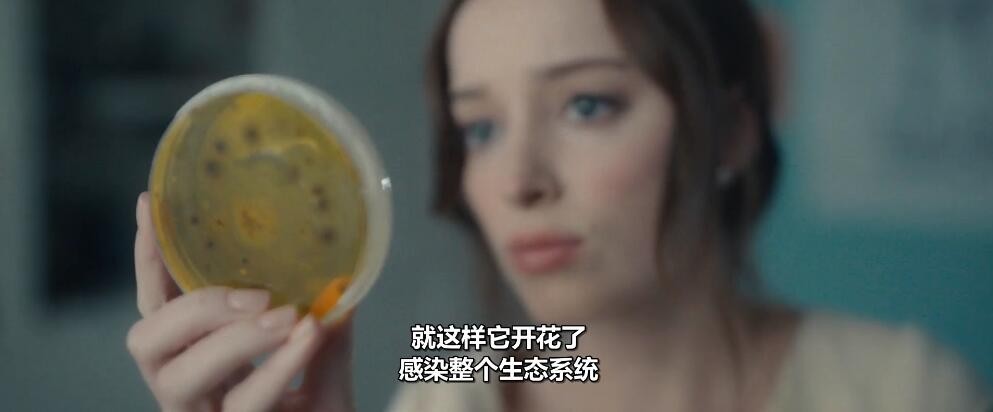

《周年纪念日2025》图集:
防走丢:»加TG群(需科学上网)«
《周年纪念日2025》剧情介绍:
原本感情深厚的一家人,因儿子带回新的女友而出现了意想不到的风暴。母亲在第一次见到这位女孩时,就隐约觉得眼熟,细想之后才意识到:自己曾在某个场合遇见她,而且对方表现出的极端言论让她心生不安。母亲试图提醒丈夫与孩子们,希望他们能警惕这段“不太单纯”的恋情,但一家人都以为她想太多,没有放在心上。
然而,就在所有人以为这只是普通的家庭矛盾时,诡异的变化悄然发生。这个神秘女孩的出现,如同一根导火索,暗中撬动着家庭的稳定。逐渐失控的行为、反常的情绪波动,以及令人无法解释的奇怪事件,让一家人一步步陷入恐惧之中。
究竟是母亲的直觉无比精准,还是背后隐藏着更深的秘密?原本温馨的家庭,被一场意料之外的噩梦彻底撕裂……
猜你喜欢:
Copyright © 2008-2026
本页面内容仅作影视信息分享与影评用途,所有影片版权归原版权方所有。
如认为本页面内容侵犯您的权益,请通过【求片留言】联系,我们将在48小时内处理。

《周年纪念日2025》精选短评: